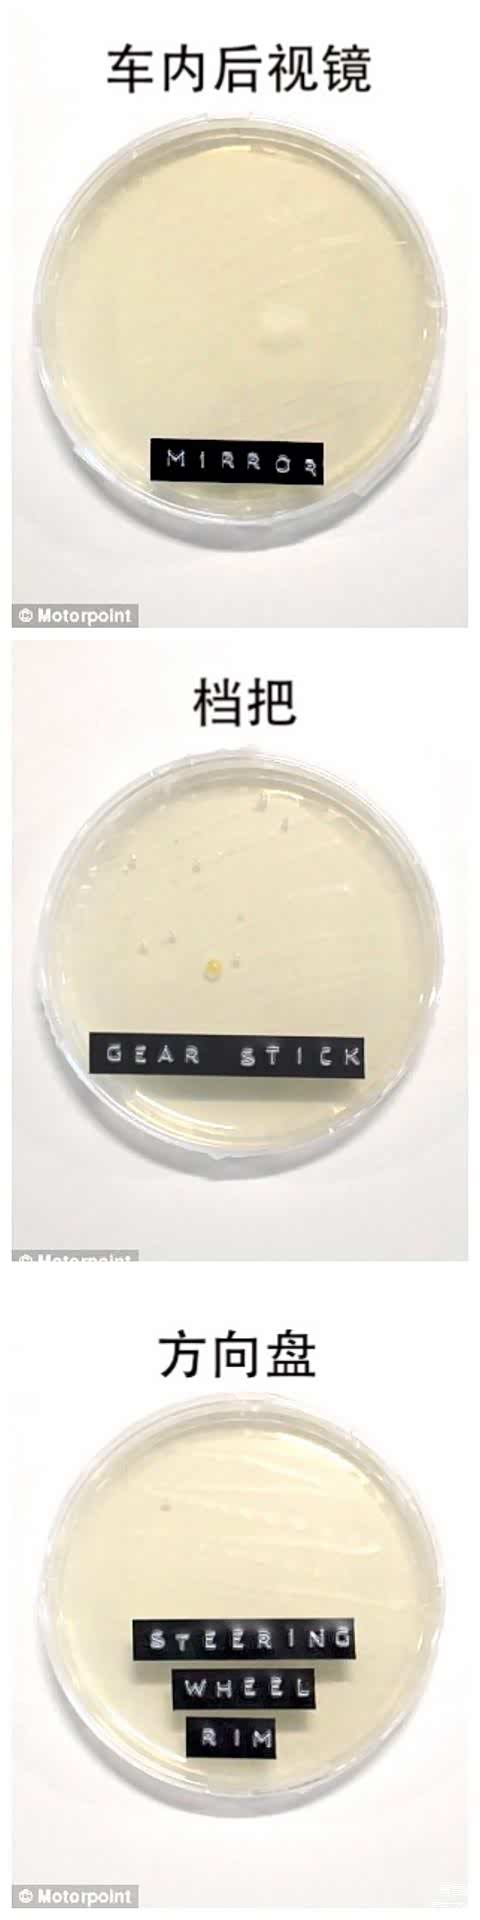
▲Motorpoint 实验中车上“最干净”的3个部位

私家车内哪儿最“脏”?慎用消毒剂防内饰“破相”
私家车是我们流动的“第二居所”,疫情之下,车内清洁工作要做好。方向盘、档把、车门拉手这样的地方,和人手接触最频繁,多数人凭直觉认为是“最脏”的,但实验数据却表明,它们却几乎是车内“最干净”的部位;消毒固然重要,但不能莽撞动手,因为车里内饰有些部位很娇气,沾上消毒剂容易变成“花脸”。
哪里“最脏”,哪里“干净”
据英国《每日快报(Daily Express)》等媒体报道,英国大型汽车销售商Motorpoint曾做过一项实验,目的是看看车内各个部位有“多脏”,进而提醒车主们养成定期清洁的习惯。
Motorpoint 借到了一部“典型”的私家车,并在车内20个不同的部位用棉签(拭子)擦拭,提取样本后进行细菌培养,以细菌数量的多少,判断该部位的“干净”程度。
结论让人大跌眼镜。
 ▲Motorpoint 实验人员从车上提取拭子样本
▲Motorpoint 实验人员从车上提取拭子样本
车内“最脏”的4个部位依次是:1、后备箱;2、驾驶位脚垫;3、安全带卡扣按钮;4、手刹。
 ▲Motorpoint 实验中车上细菌最多的4个部位
▲Motorpoint 实验中车上细菌最多的4个部位
而3个“最干净”的部位是:车内后视镜、档把和方向盘。
▲Motorpoint 实验中车上“最干净”的3个部位
▲Motorpoint 实验中车上“最干净”的3个部位
这个结果看上去很不科学,特别是方向盘和档把,整天被车主的手“盘来盘去”,似乎更容易成为细菌的乐园。但实验总比我们的直觉更靠谱,何况,这个实验不是孤例,还有美国相关机构的实验数据可以佐证。
据彭博新闻报道,美国清洁消毒用品制造商高乐氏公司(CloroxPro)选择了21辆私家车,在每辆车内13个部位用拭子取样进行细菌培养,观察每个部位的细菌数量。
 ▲彭博新闻的报道(标题大意为:CloroxPro新研究发现车内细菌最多的地方并非如人们所想)
▲彭博新闻的报道(标题大意为:CloroxPro新研究发现车内细菌最多的地方并非如人们所想)
结果发现,车内“最脏”的部位是:驾驶位脚垫(细菌数:1197);后备箱(细菌数:1180);前排座椅中间杯架(细菌数:1179);仪表台空调出风口(细菌数:1082)。
相比之下,方向盘(细菌数:408)、车门内拉手(细菌数:375)等部位比大家想象的要“干净”得多。
这两个实验结果大同小异。驾驶位的脚垫和后备箱是藏污纳垢的重点,空调出风口、安全带按钮、手刹也值得警惕,方向盘、车门拉手、档把反倒比较干净——这也许是车主经常“盘它”的成果?
车内消毒要避免内饰“破相”
搞清楚车内哪里比较“脏”,平时清洁时就要注意一下。
比如“最脏”的脚垫和后备箱垫,尽可能选用表面容易清洁的皮革或塑胶材质,洗车时用吸尘器吸干净,再用湿布擦拭,有些还可以用水冲洗。
据美国媒体报道,有传染病预防专家表示,用水洗后拧干的超细纤维布擦拭汽车内饰,可以去除大多数的细菌等微生物,只有个别比较顽固的细菌和病毒会存留下来。现在超细纤维的抹布很容易买到,平时自己可以擦擦方向盘、仪表台、车门板、档把之类的地方,搞干净了,看上去舒服,坐在车里也放心。
 ▲用湿布擦拭可去除大部分微生物
▲用湿布擦拭可去除大部分微生物
对了,要特别注意一下空调出风口和安全带扣,也是“最脏”部位之一,空调出风口如果用抹布不好擦,可以用蘸水棉签之类的东西清洁一下死角。
现在正处疫情期间,一些车主也想给自家的车消消毒。需要提醒的是,汽车内饰中有的部位比较“娇气”,与消毒剂接触后,容易出现褪色或掉皮现象。
据中国疾控中心发布的肺炎疫情下私家车预防临时指南,私家车一般情况下无需消毒处理,只要做好通风换气即可。如果搭载过健康状况不明的亲友,可以对车内相关物体表面消毒,具体方法是:选择含氯消毒剂、二氧化氯等消毒剂或消毒湿巾擦拭。
 ▲中国疾控中心发布的私家车预防临时指南中,有车内消毒的提示
▲中国疾控中心发布的私家车预防临时指南中,有车内消毒的提示
据《科技日报》报道,并不是所有的消毒剂都能杀灭冠状病毒,而乙醚、75%乙醇、含氯消毒剂、过氧乙酸和氯仿等脂溶剂均可有效灭活病毒。
我们日常生活中用到的对冠状病毒有效的消毒剂主要有两类:一类是酒精(乙醇),一类是含氯消毒剂。
酒精是一种溶剂,对汽车内饰中的塑料、皮革部位会有“腐蚀”作用;而含氯消毒剂(常见的有84消毒液、漂白粉、含氯泡腾片)都有“腐蚀”、“漂白”作用,比如有些84消毒液的使用说明中会注明:不可用于金属、丝、毛、麻、皮革等表面,对彩色织物有褪色效果。
 ▲某款84消毒液产品的使用说明
▲某款84消毒液产品的使用说明
现在皮革(包括真皮和PU、超纤等合成皮革)大量用在汽车内饰上,比如座椅、方向盘、门板、仪表台等部位,如果使用消毒剂擦拭,有可能会“擦花”,让表面变得像“皮癣”一样难看;塑料件也不能掉以轻心,一些塑料件表面是有喷漆的,一旦被擦掉,也会“破相”。
 ▲消毒剂使用不当,会导致汽车内饰表面损伤
▲消毒剂使用不当,会导致汽车内饰表面损伤
私家车内部一般是不用消毒的,如果确实需要消毒,最好谨慎一些,不管是皮革还是塑料件、金属件,最好先找不显眼的隐蔽部位做个小局部测试,确定没有问题后再动手。有些汽车品牌的4S店提供原厂认可的汽车内饰专用消毒剂,如有需要,可以买来使用。 (文/长城新媒体记者 傅雪峰)